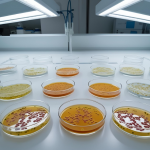

News & Article
Get the latest information on our product line and current research
-
[insight] The Significance of Precision Weighing in Analytical Chemistry
{:en}[vc_row][vc_column][vc_column_text] Precision weighing is a fundamental step in analytical chemistry, as the accuracy of sample mass directly influences calculations and analytical outcomes. Even minor deviations during
-
[guide] Tips for Setting Accurate Temperature Ranges for Lab Applications
{:en}[vc_row][vc_column][vc_column_text] Maintaining precise temperature control is essential in laboratory environments, especially for sensitive experiments and sample preservation. The first step is to carefully program the desired
-
[remark] Advancements in Heating and Cooling Block Technology
{:en}[vc_row][vc_column][vc_column_text] Heating and Cooling Block technology has evolved to meet the growing demands of complex molecular biology and biochemical research. These systems are engineered for rapid
-
[insight] Precision Temperature Control for Enzymatic Reactions and Protein Studies
{:en}[vc_row][vc_column][vc_column_text] In biochemical and molecular biology research, precise temperature control is crucial, particularly in temperature-sensitive applications like enzymatic reactions and protein crystallization. Even slight temperature deviations
-
[guide] Best Practices for Using an Automatic Media Preparator
{:en}[vc_row][vc_column][vc_column_text] Using an automatic media preparator correctly is key to ensuring consistent, sterile, and high-quality culture media. The process begins with selecting the appropriate type of
-
[remark] Automatic System for Dispensing Culture Media
{:en}[vc_row][vc_column][vc_column_text] In microbiological laboratories, consistent quality in culture media preparation is essential. Our Media Preparator offers a fully automated system for both preparing and dispensing culture
-
[insight] The Importance of Sterile Culture Media in Microbiological Studies
{:en}[vc_row][vc_column][vc_column_text] Sterile culture media are fundamental to microbiological studies, serving as the primary environment for microbial growth and analysis. Any contamination in the media can introduce
-
[guide] Conducting Compliance Testing for Tablet Disintegration
{:en}[vc_row][vc_column][vc_column_text] Compliance testing for tablet disintegration is an essential step in pharmaceutical quality assurance. The process begins by preparing the disintegration media in accordance with USP